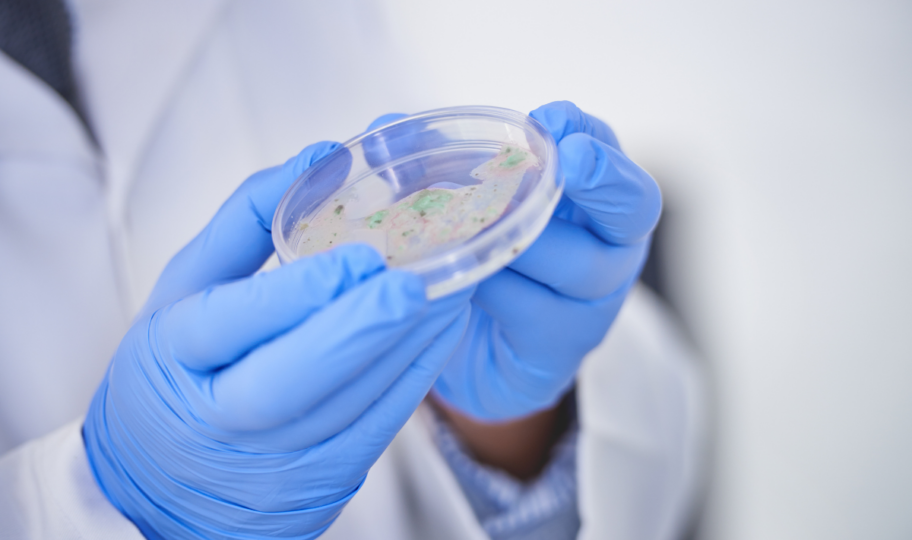
krupni kadar laboratorijskog tehničara koji u rukama drži petrijevu zdjelicu s kulturom

Salmonela odnosno salmoneloza je zarazna bolest koju uzrokuju gram-negativne štapićaste bakterije iz roda Salmonella. Uz kampilobakterioze, salmoneloze su najčešće bakterijske crijevne infekcije kod ljudi u razvijenom svijetu.
U Hrvatskoj je najveća učestalost bakterijskih crijevnih infekcija od svibnja do listopada, što s obzirom na ljetne vremenske prilike koje pogoduju razvoju bakterija i ne čudi. Voda onečišćena fekalijama, jaja i neadekvatno pasterizirani mliječni proizvodi, piletina, ali i kućni ljubimci najčešći su izvori ove potencijalno po život opasne infekcije.
Što je salmonela?
Bakterijski rod Salmonella spada u obitelj enterobakterija odnosno crijevnih bakterija koje žive u probavnom sustavu životinja i ljudi. Dvije su osnovne skupine bakterija iz ove porodice, Salmonella bongori i Salmonella enterica, a samo Salmonela enterica ima više od 2600 serotipova. Toliko velik broj serotipova otežava kontrolu infekcija i doprinosi raznolikosti u kliničkoj slici. Naime, različiti serotipovi mogu uzrokovati različite kliničke slike – od blagih proljeva do teških sistemskih infekcija, što također utječe na izbor terapije.
Serotipovi Salmonelle enterice S. Enteritidis i S. Typhimurium najčešći su uzročnici bolesti u ljudi, ali postoje i drugi koji mogu izazvati ozbiljnije, rijetke ili specifične oblike infekcija.

Kako dolazi do infekcije salmonelom?
Najčešći put zaraze salmonelama jest konzumacija zaražene hrane, koja često ni na koji način ne daje naslutiti da nešto s njom nije u redu. Osim što salmonelu možemo u organizam unijeti hranom, zaraziti se je moguće i diranjem kontaminiranih površina.
Najčešći izvori zaraze su:
- Sirova jaja i ljuske jaja
- Sirovo crveno meso, plodovi mori i perad
- Kontaminirano voće i povrće
- Nepasterizirano mlijeko ili sir
- Voda
- Krzno, perje, ljuske, kožu i izmet životinja
- Površine oko osobe koja je zaražena bakterijom Salmonella
Kada u naš organizam uđe veća količina bakterija nego što ih ono može uništiti, dolazi do infekcije.
Tko je u povećanom riziku od salmonele?
Iako salmonela “ne bira” i svatko se može zaraziti, određene skupine ljudi imaju povećan rizik od infekcije:
- Osobe koje žive ili rade u blizini životinja visokog rizika kao što su perad, kornjače i gušteri.
- Osobe koje uzimaju antacide ili antibiotike koji negativno utječu na sposobnost organizma da se obrane od infekcije salmonelom.
- Osobe koje žive s upalnom bolešću crijeva (IBD).
- Djeca mlađa od pet godina i odrasli stariji od 65.
- Osobe koje imaju oslabljen imunološki sustav uslijed infekcije HIV-om, kemoterapije (ili terapije nekim drugim lijekovima) ili neke druge bolesti.
- Osobe koje imaju anemiju srpastih stanica.
Simptomi i tijek bolesti
Salmonela ima relativno kratko razdoblje inkubacije i prvi simptomi bolesti se mogu pojaviti već šest do osam sati nakon infekcije, ali i 72 sata (prema nekim izvorima i šest dana) nakon zaraze.
Bakterije salmonele napadaju i uništavaju stanice koje oblažu crijeva (što može uzrokovati grčeve) zbog čega tijelo teško apsorbira vodu koja izlazi iz tijela u obliku proljeva. Simptomi salmonele su uglavnom gastroenterološki i uključuju sljedeće:
- Proljev
- Grčevi u želucu (abdomenu)
- Vrućica
- Mučnina
- Povraćanje
- Zimica
- Glavobolja
- Krv u stolici
Znakovi i simptomi salmonele obično traju od nekoliko dana do tjedan dana, proljev može trajati do 10 dana, ali može proći i nekoliko mjeseci prije nego što se crijeva vrate u uobičajene navike stolice.
Većina je infekcija samoograničavajuća, posebno kod zdravih osoba, i ne zahtijeva antibiotike te se liječenje obično svodi na unos tekućine i nadoknadu elektrolita.
Liječenje antibioticima se izbjegava, jer se povezuju s povećanim rizikom od recidiva bolesti, kliconoštvom i raznim nuspojavama. Primjenjuju se tek kod težih oblika, osoba s oslabljenim imunitetom ili kad bakterija uđe u krvotok ili druge organe.
Kada trebam kontaktirati liječnika?
Ako se simptomi ne poboljšaju nakon nekoliko dana, preporučuje se kontaktirati liječnika. Obavezno potražite liječničku pomoć ako uočite ozbiljnije znakove bolesti i/ili dehidracije, uključujući sljedeće:
- Visoka temperatura
- Krv u stolici
- Često povraćanje, nemogućnost zadržavanja hrane ili tekućine
- Tamno obojena mokraća ili znatno smanjena količina urina nego obično
- Suha usta ili grlo
- Osjećaj vrtoglavice pri ustajanju
Kako se postavlja dijagnoza salmonele?
Kod pacijenata s karakterističnom anamnezom te povišenom tjelesnom temperaturom obično se postavlja sumnja na salmonelu. Prisutnost salmonele se obično dokazuje izolacijom bakterija iz stolice, krvi ili urina.

Prevencija salmonele
Najsigurniji način prevencije je pasterizacija – već dvije minute na 70°C bit će dovoljni za uništavanje salmonele. Također, postoji još nekoliko načina za smanjenje rizika od zaraze tijekom pripreme hrane:
- Ne pripremajte hranu za druge ako ste bolesni.
- Uvijek operite ruke sapunom i vodom nakon odlaska u kupaonicu.
- Operite ruke prije i nakon pripreme hrane ili jela.
- Operite površine i pribor za pripremu hrane i jelo prije i nakon upotrebe.
- Ne dirajte drugu hranu dok radite sa sirovim mesom, peradi, plodovima mora ili jajima.
- Operite ili ogulite povrće i voće prije rezanja, jela ili kuhanja.
- Ne pijte nepasterizirano mlijeko ili hranu napravljenu od nepasteriziranog mlijeka.
- Ne pijte netretiranu vodu niti jedite hranu pripremljenu s netretiranom vodom.












